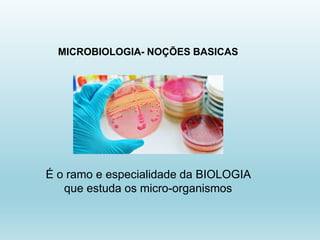
MICROBIOLOGIA- NOÇÕES BASICAS
É o ramo e especialidade da BIOLOGIA
que estuda os micro-organismos

Este documento discute os princípios básicos da higiene e segurança no trabalho. Aborda conceitos como acidentes de trabalho, doenças profissionais, riscos ocupacionais, e direitos e deveres de empregadores e trabalhadores. Também fornece exemplos de riscos comuns em restaurantes, como quedas, ferimentos por equipamentos cortantes, queimaduras e lesões musculoesqueléticas.